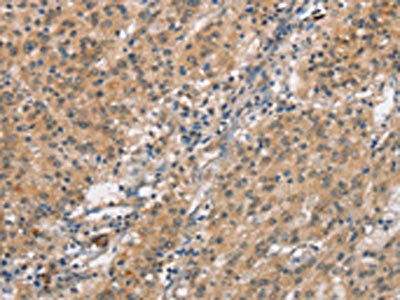

SMAD1 Antibody
-
中文名稱:SMAD1兔多克隆抗體
-
貨號:CSB-PA841004
-
規格:¥1100
-
圖片:
-
The image on the left is immunohistochemistry of paraffin-embedded Human thyroid cancer tissue using CSB-PA841004(SMAD1 Antibody) at dilution 1/40, on the right is treated with synthetic peptide. (Original magnification: ×200)
-
The image on the left is immunohistochemistry of paraffin-embedded Human gastric cancer tissue using CSB-PA841004(SMAD1 Antibody) at dilution 1/40, on the right is treated with synthetic peptide. (Original magnification: ×200)
-
Gel: 8%SDS-PAGE, Lysate: 40 μg, Lane: Mouse skeletal muscle tissue , Primary antibody: CSB-PA841004(SMAD1 Antibody) at dilution 1/800, Secondary antibody: Goat anti rabbit IgG at 1/8000 dilution, Exposure time: 3 minutes
-
-
其他:
產品詳情
-
Uniprot No.:
-
基因名:
-
別名:BSP-1 antibody; BSP1 antibody; HsMAD1 antibody; JV4-1 antibody; JV41 antibody; MAD homolog 1 antibody; MAD mothers against decapentaplegic homolog 1 antibody; Mad related protein 1 antibody; Mad-related protein 1 antibody; MADH1 antibody; MADR1 antibody; Mothers against decapentaplegic homolog 1 antibody; Mothers against DPP homolog 1 antibody; SMA- AND MAD-RELATED PROTEIN 1 antibody; SMAD 1 antibody; SMAD family member 1 antibody; SMAD mothers against DPP homolog 1 antibody; Smad1 antibody; SMAD1_HUMAN antibody; TGF beta signaling protein 1 antibody; Transforming growth factor-beta-signaling protein 1 antibody
-
宿主:Rabbit
-
反應種屬:Human,Mouse,Rat
-
免疫原:Synthetic peptide of Human SMAD1
-
免疫原種屬:Homo sapiens (Human)
-
標記方式:Non-conjugated
-
抗體亞型:IgG
-
純化方式:Antigen affinity purification
-
濃度:It differs from different batches. Please contact us to confirm it.
-
保存緩沖液:-20°C, pH7.4 PBS, 0.05% NaN3, 40% Glycerol
-
產品提供形式:Liquid
-
應用范圍:ELISA,WB,IHC
-
推薦稀釋比:
Application Recommended Dilution ELISA 1:1000-1:2000 WB 1:200-1:1000 IHC 1:50-1:200 -
Protocols:
-
儲存條件:Upon receipt, store at -20°C or -80°C. Avoid repeated freeze.
-
貨期:Basically, we can dispatch the products out in 1-3 working days after receiving your orders. Delivery time maybe differs from different purchasing way or location, please kindly consult your local distributors for specific delivery time.
-
用途:For Research Use Only. Not for use in diagnostic or therapeutic procedures.
相關產品
靶點詳情
-
功能:Transcriptional modulator activated by BMP (bone morphogenetic proteins) type 1 receptor kinase. SMAD1 is a receptor-regulated SMAD (R-SMAD). SMAD1/OAZ1/PSMB4 complex mediates the degradation of the CREBBP/EP300 repressor SNIP1. May act synergistically with SMAD4 and YY1 in bone morphogenetic protein (BMP)-mediated cardiac-specific gene expression.
-
基因功能參考文獻:
- miR-26a-5p is highly expressed in synovial tissue of patients with RA, and its high expression can improve the invasive ability of synovial fibroblasts by targeting Smad 1 gene and accelerating the progression of RA. PMID: 30046030
- miR-23a facilitated cell proliferation and migration by targeting BMPR2/Smad1 signaling in hypoxia-induced human pulmonary artery smooth muscle cells. PMID: 29864909
- the expression of BMP15 in follicular fluid and Smad1 in granulosa cells was significantly decreased in the PCOS group compared with the control (P<0.05). The data suggested that the BMP15/Smad1 signalling pathway may be involved in granulosa cell apoptosis PMID: 28983616
- Mechanical stress affects the osteogenic differentiation of human ligamentum flavum cells via the BMP-Smad1 signaling pathway. PMID: 28944874
- Urinary Smad1 was associated with the degree of mesangial expansion in early diabetic nephropathy. PMID: 29490904
- Differential expression of TGF-beta superfamily members and role of Smad1/5/9-signalling in chondral versus endochondral chondrocyte differentiation. PMID: 27848974
- Uev1A appears to be involved in the BMP signaling pathway in which it collaborates with a ubiquitin E3 ligase Smurf1 to promote Smad1 degradation in a Ubc13-independent manner. PMID: 28771228
- Data show that miR-26b-5p suppresses Twist1-induced EMT, invasion, and metastasis of HCC cells by targeting SMAD1. PMID: 27027434
- Testosterone promoted tube formation of human umbilical endothelial cells, which was blocked by c-Src and ERK1/2 inhibitors or by the knockdown of Smad1. PMID: 28167128
- Low doses of IL1B activate the BMP/Smad signaling pathway to promote the osteogenesis of periodontal ligament stem cells, but higher doses of IL1B inhibit BMP/Smad signaling through the activation of NF-kappaB and MAPK signaling, inhibiting osteogenesis. PMID: 27415426
- Store operated calcium entry negatively regulates the Smad1 signaling pathway and inhibits Col IV protein production in glomerular mesangial cells. PMID: 28298362
- A significant association was found between the low expression of inhibitory protein SMAD-7 and both zeta-chain-associated protein kinase 70-negative cells (p = 0.04) and lower apoptotic index (p = 0.004). No differences were observed in SMAD-2/3 expression. In conclusion, our results demonstrate a significant correlation between greater SMAD-1/8 and lower SMAD-4 expression in chronic lymphocytic leukemia cells PMID: 28349818
- melatonin treatment was found to downregulate TNFalpha-induced SMURF1 expression and then decrease SMURF1-mediated ubiquitination and degradation of SMAD1 protein PMID: 27265199
- The expression of specific targets Smad1 and Osterix was significantly increased in the presence of Pi and restored by coincubation with Mg(2+). As miR-30b, miR-133a, and miR-143 are negatively regulated by Pi and restored by Mg(2+) with a congruent modulation of their known targets Runx2, Smad1, and Osterix, our results provide a potential mechanistic explanation of the observed upregulation of these master switches of o PMID: 27419135
- the BMP-2/Smad1/5/RUNX2 signaling pathway participates in the silicon-mediated induction of COL-1 and osteocalcin synth PMID: 27025722
- Regulation of impaired angiogenesis in diabetic dermal wound healing by microRNA-26a is mediated by the increased expression of its target gene, SMAD1. PMID: 26776318
- The expression SMAD1 protein showed a significant correlation with lung cancer differentiation and lymphatic metastasis (P < 0.05), but not with genders, ages, tumor sizes and histological types of lung cancer patients (P>0.05). PMID: 27049088
- Overexpression of Smad1 is associated with prostate cancer. PMID: 26227059
- SMAD1 signaling may be a key pathway contributing the pathogenesis of Cardio-facio-cutaneous syndrome during early development. PMID: 25639853
- Smad1 elevation serves as a compensatory mechanism for p53 deficiency by potentiating the activation of p53 parallel pathways. PMID: 25757624
- Our data indicated that downregulation of miR-26b in osteosarcoma elevated the levels of CTGF and Smad1, facilitating osteosarcoma metastasis PMID: 25761878
- Smad1 as a novel binding protein of KSHV latency-associated nuclear antigen (LANA). LANA interacted with and sustained BMP-activated p-Smad1 in the nucleus and enhanced its loading on the Id promoters. PMID: 25010525
- adult human Sertoli cells assumed similar morphological features, stable global gene expression profiles and numerous proteins, and activation of AKT and SMAD1/5 during long-period culture. PMID: 25880873
- balance between Smad1/5- and Smad2/3-dependent signaling defines the outcome of the effect of TGF-beta on atherosclerosis where Smad1/5 is responsible for proatherogenic effects PMID: 25505291
- Data show that USP15 enhances BMP-induced phosphorylation of SMAD1 by interacting with and deubiquitylating ALK3. PMID: 24850914
- urinary Smad1 may be a potential diagnostic parameter for diabetic nephropathy and may be used to evaluate the severity of diabetic nephropathy PMID: 23943254
- Inhibiting Smurf1 mediated ubiquitination of Smad1/5. PMID: 24828823
- Smad1 is directly downregulated by miR-205. mRNA levels are not affected but Smad1 protein is decreased by miR-205 overexpression and increased by miR-205 inhibition. PMID: 23800974
- Results indicate that BMP/Smad signaling pathway was altered during the period of osteogenesis, and that the activities of p-Smad1/5 were required for Saos-2 cells viability and differentiation induced by fluoride. PMID: 23918166
- Glucocorticoids recruit Tgfbr3 and Smad1 to shift transforming growth factor-beta signaling from the Tgfbr1/Smad2/3 axis to the Acvrl1/Smad1 axis in lung fibroblasts. PMID: 24347165
- the shear-induced apoptosis and autophagy are mediated by bone morphogenetic protein receptor type (BMPR)-IB, BMPR-specific Smad1 and Smad5, and p38 mitogen-activated protein kinase. PMID: 24021264
- a detailed computational model for TGF-beta signalling that incorporates elements of previous models together with crosstalking between Smad1/5/8 and Smad2/3 channels through a negative feedback loop dependent on Smad7. PMID: 23804438
- Data indicate a transcription complex androgen receptor (AR)-p44-Smad1, and confirmed for physical interaction by co-immunoprecipitaion. PMID: 23734213
- our studies establish that loss of SMAD1/5 leads to upregulation of PDGFA in ovarian granulosa cells PMID: 22964636
- Oscillatory shear stress induces synergistic interactions between specific BMPRs and integrin to activate Smad1/5 through the Shc/FAK/ERK pathway PMID: 23387849
- shows role of ALK-1 in many process related to cardiovascular homeostasis, and the involvement of this protein in the development of cardiovascular diseases, suggesting the possibility of using the ALK-1/smad-1 pathway as a powerful therapeutic target PMID: 23707512
- TNF activated NF-kappaB pathway and inhibited the phosphorylation of Smad 1/5/8 and BMP-2-induced osteoblastic differentiation in BMMSCs PMID: 22897816
- Immunohistochemical analysis furthermore revealed that phosphorylated Smad1/5/8 and endoglin expression were significantly higher in high-grade compared to low-grade chondrosarcoma and correlated to each other. PMID: 23088614
- Immunohistochemical analysis of phosphorylated Smad1 showed nuclear expression in 70% of the osteosarcoma samples at levels comparable to osteoblastoma. Cases with lower expression showed significantly worse disease free survival. PMID: 22868198
- Cav-1 is required and sufficient for Smad1 signaling in human dermal fibroblasts. PMID: 22277251
- Data suggest that Smads 1, 5 and 8 as potential prognostic markers and therapeutic targets for mTOR inhibition therapy of prostate cancer. PMID: 22452883
- TGF-beta induces the formation of complexes comprising phosphorylated Smad1/5 and Smad3, which bind to BMP-responsive elements in vitro and in vivo and mediate TGF-beta-induced transcriptional repression. PMID: 22615489
- Force-specific activation of Smad1/5 regulates vascular endothelial cell cycle progression in response to disturbed flow. PMID: 22550179
- Smurf1 is a negative feedback regulator for IFN-gamma signaling by targeting STAT1 for ubiquitination and proteasomal degradation. PMID: 22474288
- PAK2 negatively modulate TGF-beta signaling by attenuating the receptor-Smad interaction and thus Smad activation PMID: 22393057
- BMP-9 induced endothelial cell tubule formation and inhibition of migration involves Smad1 driven endothelin-1 production. PMID: 22299030
- Urinary Smad1 is a sensitive biomarker for diagnosis of diabetic glomerulosclerosis. PMID: 22073863
- Results show that BMP4-induced changes in OvCa cell morphology and motility are Smad-dependent with shRNA targeting Smads 1, 4, and 5. PMID: 21945631
- Expression of mutated Smad1 in adult human MSC cultures also resulted in increased nuclear accumulation of BMP-activated Smads and elevated gene transcripts characteristic of differentiating osteoblasts PMID: 21405981
- Endoglin promotes fibrosis in scleroderma fibroblasts via TGF-beta/Smad1 signaling. PMID: 21344387
顯示更多
收起更多
-
相關疾病:SMAD1 variants may be associated with susceptibility to pulmonary hypertension, a disorder characterized by plexiform lesions of proliferating endothelial cells in pulmonary arterioles. The lesions lead to elevated pulmonary arterial pression, right ventricular failure, and death. The disease can occur from infancy throughout life and it has a mean age at onset of 36 years. Penetrance is reduced. Although familial pulmonary hypertension is rare, cases secondary to known etiologies are more common and include those associated with the appetite-suppressant drugs.
-
亞細胞定位:Cytoplasm. Nucleus.
-
蛋白家族:Dwarfin/SMAD family
-
組織特異性:Ubiquitous. Highest expression seen in the heart and skeletal muscle.
-
數據庫鏈接:
Most popular with customers
-
-
YWHAB Recombinant Monoclonal Antibody
Applications: ELISA, WB, IHC, IF, FC
Species Reactivity: Human, Mouse, Rat
-
Phospho-YAP1 (S127) Recombinant Monoclonal Antibody
Applications: ELISA, WB, IHC
Species Reactivity: Human
-
-
-
-
-